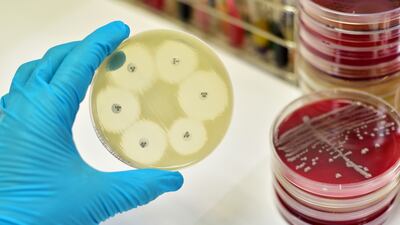

Uganda
Country
Stay up to date on regulatory guidelines from around the world with the Pink Sheet's Guidance Tracker. The complete Global Pharma Guidance Tracker, with sortable and searchable listings going back to 2014, is available online.
Stay up to date on regulatory guidelines from around the world with the Pink Sheet's Guidance Tracker. The complete Global Pharma Guidance Tracker, with sortable and searchable listings going back to 2014, is available online.
Stay up to date on regulatory guidelines from around the world with the Pink Sheet's Guidance Tracker. The complete Global Pharma Guidance Tracker, with sortable and searchable listings going back to 2014, is available online.
Stay current on regulatory guidelines from around the world with Medtech Insight's Guidance Tracker. Over 40 documents have been posted on the tracker since its last update.
Stay up to date on regulatory guidelines from around the world with the Pink Sheet's Guidance Tracker. The complete Global Pharma Guidance Tracker, with sortable and searchable listings going back to 2014, is available online.
Stay up to date on regulatory guidelines from around the world with the Pink Sheet's Guidance Tracker. The complete Global Pharma Guidance Tracker, with sortable and searchable listings going back to 2014, is available online.
Stay up to date on regulatory guidelines from around the world with the Pink Sheet's Guidance Tracker. The complete Global Pharma Guidance Tracker, with sortable and searchable listings going back to 2014, is available online.
Stay up to date on regulatory guidelines from around the world with the Pink Sheet's Guidance Tracker. The complete Global Pharma Guidance Tracker, with sortable and searchable listings going back to 2014, is available online.
Stay current on regulatory guidelines from around the world with Medtech Insight's Guidance Tracker. Thirty-six documents have been posted on the tracker since its last update.
Stay up to date on regulatory guidelines from around the world with the Pink Sheet's Guidance Tracker. The complete Global Pharma Guidance Tracker, with sortable and searchable listings going back to 2014, is available online.
Stay current on regulatory guidelines from around the world with Medtech Insight's Guidance Tracker. Thirty-nine documents have been posted on the tracker since its last update.
Stay up to date on regulatory guidelines from around the world with the Pink Sheet's Guidance Tracker. The complete Global Pharma Guidance Tracker, with sortable and searchable listings going back to 2014, is available online.
Stay up to date on regulatory guidelines from around the world with the Pink Sheet's Guidance Tracker. The complete Global Pharma Guidance Tracker, with sortable and searchable listings going back to 2014, is available online.
Stay up to date on regulatory guidelines from around the world with the Pink Sheet's Guidance Tracker. The complete Global Pharma Guidance Tracker, with sortable and searchable listings going back to 2014, is available online.
Stay up to date on regulatory guidelines from around the world with the Pink Sheet's Guidance Tracker. The complete Global Pharma Guidance Tracker, with sortable and searchable listings going back to 2014, is available online.
Stay current on regulatory guidelines from around the world with Medtech Insight's Guidance Tracker. Thirty-eight guidance documents have been posted on the tracker since its last update.
Stay up to date on regulatory guidelines from around the world with the Pink Sheet's Guidance Tracker. The complete Global Pharma Guidance Tracker, with sortable and searchable listings going back to 2014, is available online.
Stay up to date on regulatory guidelines from around the world with the Pink Sheet's Guidance Tracker. The complete Global Pharma Guidance Tracker, with sortable and searchable listings going back to 2014, is available online.
A new project devised by Pfizer and the Wellcome Trust aims to tackle antimicrobial resistance (AMR) in four sub-Saharan African countries by using real world data to track resistance patterns and allow patients to be treated more successfully. Wellcome’s Gemma Buckland-Merrett explains how the project will work and how it could help other industry partners and governments to generate valuable data in the fight against AMR.
Stay up to date on regulatory guidelines from around the world with the Pink Sheet's Guidance Tracker. The complete Global Pharma Guidance Tracker, with sortable and searchable listings going back to 2014, is available online.
ADVERTISEMENT